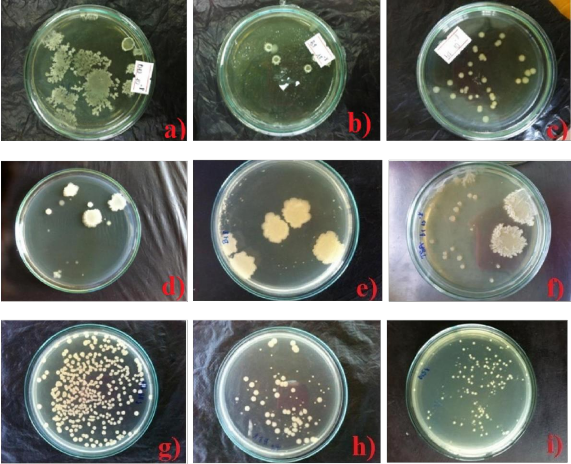
Hình 1 4 Các dòng vi khuẩn và các phản ứng sinh hóa Hình 1 5 Định tính khả năng 2
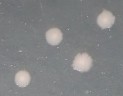
Đại thể Khuẩn lạc tròn nhầy màu trắng sữa rìa răng cưa Vi thể Tế bào 7
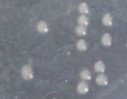
Đại thể Khuẩn lạc tròn lồi nhầy màu trắng hơi vàng Vi thể tế bào gram 11
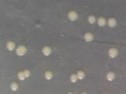
Đại thể Khuẩn lạc tròn lồi nhầy màu vàng nhạt Vi thể tế bào hình que 13
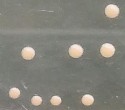
Đại thể Khuẩn lạc tròn lồi nhầy bóng nhớt màu hồng dâu Vi thể Tế 16
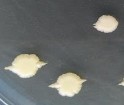
Đại thể Khuẩn lạc tròn lồi nhầy màu trắng đục khuẩn lạc nhăn ở rìa 18

1.2 Phân lập, định danh vi khuẩnBacillus và khảo sát khả năng chuyển hóa ammonia của các dòng vi khuẩn Bacillus

Hình 1.3 Một số hình ảnh thu mẫu ở Vịnh Xuân Đài
1.2.1 Môi trường trypticase soya agar (TSA) ( phân lập Bacillus )
Soya peptone 15g
Tryptone peptone 5g
Agar 18g
NaCl 5g
Nước cất 1000ml
pH 7,3
1.2.2 Hình ảnh các dòng vi khuẩn Bacillus và phản ứng sinh hóa.
Hình 1.4 Các dòng vi khuẩn và các phản ứng sinh hóa


Hình 1.5 Định tính khả năng chuyển hóa ammonia của Bacillus sp.
Khóa phân loại Bergey của nhóm vi khuẩn Bacillus sp.

1.2.3 Kết quả định danh sinh học phân tử
Kết quả giải trình tự dòng B2 AGTGCCTTTCTGGTTAGGTACCGTCAAGGTGCCGCCCTATTTAGAACGGCACTTGTTCT TCCCTAACAACAGAGCTTTACGATCCGAAAACCTTCATCACTCACGCGGCGTTGCTCC
GTCAGACTTTCGTCCATTGCGGAAGATTCCCTACTGCTGCCTCCCGTAGGAGTCTGGGC
CGTGTCTCAGTCCCAGTGTGGCCGATCACCCTCTCAGGTCGGCTACGCATCGTCGCCTT GGTGAGCCGTTACCTCACCAACTAGCTAATGCGCCGCGGGTCCATCTGTAAGTGGTAG CCGAAGCCACCTTTTATGTCTGAACCATGCGGTTCAAACAACCATCCGGTATTAGCCC CGGTTTCCCGGAGTTATCCCAGTCTTACAGGCAGGTTACCCACGTGTTACTCACCCGTC CGCCGCTAACATCAGGGAGCAAGCTCCCATCTGTCCGCTCGACTTGCATGTATTAGGC ACGCCGCCAGCGTTCGTCCTGAGCCAGGATCCAAAAATAAACCCA
Kết quả giải trình tự dòng B5 TGGTGGGGGGGGAAGAACAAATACTTGCAAGTCGAGCGGACAGATGGGAGCTTGCTC CCTGATGTTAGCGGCGGACGGGTGAGTAACACGTGGGTAACCTGCCTGTAAGACTGGG ATAACTCCGGGAAACCGGGGCTAATACCGGATGGTTGTTTGAACCGCATGGTTCAAAC ATAAAAGGTGGCTTCGGCTACCACTTACAGATGGACCCGCGGCGCATTAGCTAGTTGG TGAGGTAACGGCTCACCAAGGCAACGATGCGTAGCCGACCTGAGAGGGTGATCGGCC ACACTGGGACTGAGACACGGCCCAGACTCCTACGGGAGGCAGCAGTAGGGAATCTTC CGCAATGGACGAAAGTCTGACGGAGCAACGCCGCGTGAGTGATGAAGGTTTTCGGAT CGTAAAGCTCTGTTGTTAGGGAAGAACAAGTACCGTTCGAATAGGGCGGTACCTTGAC GGTACCTAACCAGAAAGCCACGGCTAACTACGTGCCAGCAGCCGCGGTAAAAACACC
Kết quả giải trình tự dòng B31 ATCGGGTGGCCTTTCTGGTTAGGTACCGTCAAGGTGCCGCCCTATTTGAACGGCACTTG TTCTTCCCTAACAACAGAGCTTTACGATCCGAAAACCTTCATCACTCACGCGGCGTTGC TCCGTCAGACTTTCGTCCATTGCGGAAGATTCCCTACTGCTGCCTCCCGTAGGAGTCTG GGCCGTGTCTCAGTCCCAGTGTGGCCGATCACCCTCTCAGGTCGGCTACGCATCGTCG CCTTGGTGAGCCGTTACCTCACCAACTAGCTAATGCGCCGCGGGTCCATCTGTAAGTG GTAGCCGAAGCCACCTTTTATGTCTGAACCATGCGGTTCAAACAACCATCCGGTATTA GCCCCGGTTTCCCGGAGTTATCCCAGTCTTACAGGCAGGTTACCCACGTGTTACTCACC CGTCCGCCGCTAACATCAGGGAGCAAGCTCCCATCTGTCCGCTCGACTTGCATGTATT AGGCACGCCGCCAGCGTTCGTCCTGAGCCAGGATCAAACTCTCAAA
Kết quả giải trình tự dòng B58 AGGGGGGGAACGTTGCCTAATAAATGCAAGTCGAGCGGACAGATGGGAGCTTGCTCC CTGATGTTAGCGGCGGACGGGTGAGTAACACGTGGGTAACCTGCCTGTAAGACTGGGA TAACTCCGGGAAACCGGGGCTAATACCGGATGGTTGTCTGAACCGCATGGTTCAGACA TAAAAGGTGGCTTCGGCTACCACTTACAGATGGACCCGCGGCGCATTAGCTAGTTGGT GAGGTAACGGCTCACCAAGGCGACGATGCGTAGCCGACCTGAGAGGGTGATCGGCCA CACTGGGACTGAGACACGGCCCAGACTCCTACGGGAGGCAGCAGTAGGGAATCTTCC GCAATGGACGAAAGTCTGACGGAGCAACGCCGCGTGAGTGATGAAGGTTTTCGGATC GTAAAGCTCTGTTGTTAGGGAAGAACAAGTGCCGTTCAAATAGGGCGGCACCTTGACG GTACCTAACCAGAAAGCCACGGCTAACTACGTGCCAGCAGCCGCCGGTAATAAAA
Kết quả giải trình tự dòng B68 AGTTGGGGGGCGTGCCTATACTGCAAGTCGAGCGGACAGATGGGAGCTTGCTCCCTGA TGTTAGCGGCGGACGGGTGAGTAACACGTGGGTAACCTGCCTGTAAGACTGGGATAAC TCCGGGAAACCGGGGCTAATACCGGATGGTTGTCTGAACCGCATGGTTCAGACATAAA AGGTGGCTTCGGCTACCACTTACAGATGGACCCGCGGCGCATTAGCTAGTTGGTGAGG TAACGGCTCACCAAGGCGACGATGCGTAGCCGACCTGAGAGGGTGATCGGCCACACT GGGACTGAGACACGGCCCAGACTCCTACGGGAGGCAGCAGTAGGGAATCTTCCGCAA TGGACGAAAGTCTGACGGAGCAACGCCGCGTGAGTGATGAAGGTTTTCGGATCGTAA AGCTCTGTTGTTAGGGAAGAACAAGTGCCGTTCAAATAGGGCGGCACCTTGACGGTAC CTAACCAGAAAGCCACGGCTAACTACGTGCCAGCAGCCGCCGGTAATAAAA
Kết quả giải trình tự dòng B74 CCGTGGCTTTTCTGGTTAGGTACCGTCAAGGTACCGCCCTATTCGAACGGTACTTGTTC TTCCCTAACAACAGAGCTTTACGATCCGAAAACCTTCATCACTCACGCGGCGTTGCTCC GTCAGACTTTCGTCCATTGCGGAAGATTCCCTACTGCTGCCTCCCGTAGGAGTCTGGGC CGTGTCTCAGTCCCAGTGTGGCCGATCACCCTCTCAGGTCGGCTACGCATCGTTGCCTT GGTGAGCCGTTACCTCACCAACTAGCTAATGCGCCGCGGGTCCATCTGTAAGTGGTAG CCAAAGCCACCTTTTATGTTTGAACCATGCGGTTCAAACAACCATCCGGTATTAGCCCC GGTTTCCCGGAGTTATCCCAGTCTTACAGGCAGGTTACCCACGTGTTACTCACCCGTC GCCGCTAACATCAGGGAGCAAGCTCCCATCTGTCCGCTCGACTTGCATGTATTAGGCA CGCCGCCAGCGTTCGTCCTGAGCCAGAATCAAAACTCTCCAA
Kết quả giải trình tự dòng B85 ACCCTTGCTTTTCTGGTAAGGTACCGTCAAGGTACCGCCCTATTCGAACGGTACTTGTT CTTCCCTAACAACAGAGCTTTACGATCCGAAAACCTTCATCACTCACGCGGCGTTGCTC CGTCAGACTTTCGTCCATTGCGGAAGATTCCCTACTGCTGCCTCCCGTAGGAGTCTGGG CCGTGTCTCAGTCCCAGTGTGGCCGATCACCCTCTCAGGTCGGCTACGCATCGTTGCCT TGGTGAGCCATTACCTCACCAACTAGCTAATGCGCCGCGGGTCCATCTGTAAGTGGTA GCCGAAGCCACCTTTTATGTTTGAACCATGCGGTTCAAACAACCATCCGGTATTAGCCC CGGTTTCCCGGAGTTATCCCAGTCTTACAGGCAGGTTACCCACGTGTTACTCACCCGTC CGCCGCTAACATCAGGGAGCAAGCTCCCATCTGTCCGCTCGACTTGCATGTATTAGGC ACGCCGCCAGCGTTCGTCCTGAGCCAGGATCCAAACTCAATCAA
Kết quả giải trình tự dòng B91 AGGGGCCGGGGTGCCTATAATGCAAGTCGAGCGGACAGATGGGAGCTTGCTCCCTGAT GTTAGCGGCGGACGGGTGAGTAACACGTGGGTAACCTGCCTGTAAGACTGGGATAACT CCGGGAAACCGGGGCTAATACCGGATGGTTGTTTGAACCGCATGGTTCAGACATAAAA GGTGGCTTCGGCTACCACTTACAGATGGACCCGCGGCGCATTAGCTAGTTGGTGAGGT AACGGCTCACCAAGGCGACGATGCGTAGCCGACCTGAGAGGGTGATCGGCCACACTG
GGACTGAGACACGGCCCAGACTCCTACGGGAGGCAGCAGTAGGGAATCTTCCGCAAT GGACGAAAGTCTGACGGAGCAACGCCGCGTGAGTGATGAAGGTTTTCGGATCGTAAA GCTCTGTTGTTAGGGAAGAACAAGTGCCGTTCAAATAGGGCGGCACCTTGACGGTACC TAACCAGAAAGCCACGGCTAACTACGTGCCAGCAGCCGCCGGTAATAAACA.
1.2.4 Hiệu suất chuyển hóa ammonia của 13 dòng vi khuẩn Bacillus sp.
Bảng 1.1 Số liệu hiệu suất chuyển hóa ammonia của 7 dòng vi khuẩn Bacillus sp.
Hàm lượng NH4+ (mg/L) chuyển hóa
hóa (%) | ||||||
B2 | 0,576b±0,03 | 0,408bc±0,05 | 0,199de±0,02 | 0,104cd±0,02 | 0,041c±0,01 | 88,6 |
B7 | 0,358d±0,03 | 0,227d±0,04 | 0,155e±0,02 | 0,068d±0,01 | 0,035c±0,01 | 92,6 |
B9 | 0,469c±0,03 | 0,354bcd±0,05 | 0,215bcde±0,03 | 0,148bc±0,02 | 0,064bc±0,03 | 83,8 |
B11 | 0,564b±0,03 | 0,460b±0,01 | 0,246bcd±0,06 | 0,162bc±0,06 | 0,074bc±0,03 | 82,3 |
B12 | 0,525bc±0,04 | 0,356bcd±0,03 | 0,237bcde±0,03 | 0,167bc±0,04 | 0,089bc±0,05 | 81,8 |
B18 | 0,469c±0,03 | 0,354bcd±0,06 | 0,198de±0,06 | 0,129bcd±0,03 | 0,085bc±0,04 | 85,9 |
B91 | 0,530bc±0,02 | 0,366bcd±0,05 | 0,205cde±0,03 | 0,172bc±0,02 | 0,143b±0,01 | 81,2 |
Có thể bạn quan tâm!
-
Guan. X & Yao. H., 2008. Optimization Of Viscozyme L-Assisted Extraction Of Oat Bran Protein Using Response Surface Methodology. Food Chemistry 106 (1): 345-351. -
Nghiên cứu vi khuẩn chuyển hóa nitơ trong nền đáy vùng nuôi tôm hùm panulirus sp. phục vụ nuôi trồng thủy sản - 21 -
Khảo Sát Hàm Lượng Mật Rỉ Của P. Stutzeri Kl15 33 -
Hình Ảnh Tra Phần Mềm Phản Ứng Sinh Hóa Của Nhóm Vi Khuẩn Aob/nob -
Kết Quả Sinh Hóa Để Xác Định 2 Chủng Vi Khuẩn C9/1, T5/3 Thuộc Chi Bacillus Sp. ( Khóa Phân Loại Bergey). -
Đường Tuyến Tính Mật Số Vi Sinh Vật Với Od600Nm
Xem toàn bộ 247 trang tài liệu này.
Chủng vi khuẩn
6 12 24 36 48 Hiệu suất chuyển
Trong cùng một cột, các giá trị có ký tự theo sau giống nhau không có sự khác biệt về mặt thống kê (P < 0,01).
Bảng 1.2 Số liệu hiệu suất chuyển hóa ammonia của 6 dòng vi khuẩn Bacillus sp (Hình 3.2)
Hàm lượng NH4+ (mg/L) chuyển hóa | ||||||
B5 | B31 | B58 | B68 | B74 | B85 | |
6 | 0,233c ± 0,1 | 0,862b ± 0,1 | 1,973a ± 0,1 | 0,751b ±0,01 | 1,973a±0,1 | 1,010b ± 0,064 |
12 | 3,146a ± 0,1 | 1,073c ± 0,1 | 2,221b ± 0,064 | 3,220a± 0,11 | 2,221b ±0,064 | 2,332b ± 0,064 |
24 | 8,987b ± 0,08 | 10,515a± 0,1 | 8,198c ±0,034 | 8,404c±0,12 | 8,254c ± 0,1 | 9,046b ± 0,063 |
36 | 0,468a ± 0,01 | 0,211c ± 0,034 | 0,305bc ±0,006 | 0,509a0,14 | 0,248c ±0,009 | 0,417ab ± 0,062 |
48 | 0,040c ±0,003 | 0,121bc ±0,013 | 0,267a ± 0,002 | 0,074c ±0,04 | 0,187b±0,029 | 0,155b ± 0,02 |
Hiệu suất chuyển hóa (%) | 99,7 | 99,1 | 97,9 | 99,4 | 98,6 | 98,8 |
Trong cùng một cột, các giá trị có ký tự theo sau giống nhau không có sự khác biệt về mặt thống kê (P < 0,05).
1.3 Phân lập, định danh vi khuẩn AOB và khảo sát khả năng chuyển hóa ammonia của nhóm vi khuẩn
1.3.1 Thành phần môi trường
Môi trường phân lập vi khuẩn: môi trường ammonium-calcium-carbonate được sử dụng để phân lập vi khuẩn dựa theo phương pháp của Ehrlich (1975)
(NH4)2SO4 0,5g
K2HPO4 1g
FeSO4.7H2O 0,03g
NaCl 0,3g
MgSO4.7H2O 0,3g
CaCO3 7,5g
Môi trường nuôi tăng sinh vi khuẩn được chuẩn bị theo công thức môi trường của Lewis và Pramer (1958) và MacDonad và Spokes (1980).
Na2HPO4 13,5g
KH2PO4 0,7g
MgSO4.7H2O 0,1g
NaHCO3 0,5g
(NH4)2SO4 2,5g
FeCl3.6H2O 0,0142g
CaCl2.2H2O 0,0184g
Thuốc thử Griess – Ilosway dùng để kiểm tra sự hiện diện của NO2- bao gồm dung dịch A (thuốc thử acid sulfanilic), dung dịch B (thuốc thử N –(1-naphthyl) ethylenediamine) và dung dịch C (thuốc thử alpha- Naphthol) được chuẩn bị sẳn.
Một ít Tris HCl được thêm vào để tránh sự kết tủa của các nguyên tố vi lượng trong môi trường (thể tích 1000 ml nước cất). (NH4)2SO4 được tiệt trùng chuyên biệt sau đó thêm vào dung dịch môi trường trong điều kiện vô trùng.
1.3.2 Tuyển chọn và phân lập nhóm vi khuẩn chuyển hóa ammonia

Ghi chú: trắng (-), đỏ (+)
Hình 1.6 Sự hiện diện của nhóm AOB trong mẫu bùn
Bảng 1.3 Mật độ vi khuẩn của nhóm AOB trong mẫu bùn
Ký hiệu mẫu | MPN /gam | STT | Ký hiệu mẫu | MPN /gam | |
1 | BT1 | 1,5 x 104 | 12 | BC12 | 1,6 x 103 |
2 | BT2 | 1,5 x 104 | 13 | BC13 | 2,4 x 103 |
3 | BT3 | 4,3 x 103 | 14 | BC14 | 1,5 x 104 |
4 | BT4 | 1,2 x 104 | 15 | BC15 | 1,6 x 103 |
5 | BT5 | 7,5 x 103 | 16 | BC16 | 2,4 x 103 |
6 | BT6 | 7,5 x 103 | 17 | BC17 | 2,1 x 103 |
7 | BT7 | 4,3 x 103 | 18 | BC18 | 2,8 x 103 |
8 | BT8 | 2,1 x 104 | 19 | BC19 | 2,4 x 103 |
9 | BT9 | 1,5 x 104 | 20 | BC20 | 2,1 x 103 |
10 | BT10 | 9,3 x 103 | 21 | BC21 | 2,4 x 103 |
11 | BC11 | 0,9 x 103 | 22 | NTĐC | < 3 |
Bảng 1.4 Định tính khả năng chuyển hóa ammonia của các dòng vi khuẩn AOB
Chuyển hóa NH3 | Dòng | Chuyển hóa NH3 | |
KL1 | ++ | KL19 | + |
KL2 | + + + + | KL20 | ++ |
KL3 | + | KL21 | + + + + |
KL4 | + + + | KL22 | + |
KL5 | + + | KL23 | + ++ |
+ | KL24 | + | |
KL7 | + | KL25 | + + |
KL8 | + + | KL26 | + + + + |
KL9 | + + | KL27 | + + |
KL10 | + + + + | KL28 | + |
KL11 | + + + + | KL29 | + |
KL12 | + | KL30 | + + + + |
KL13 | + | KL31 | + |
KL14 | + + + + | KL32 | + |
KL15 | + + + + | KL33 | + + + + |
KL16 | +++ | KL34 | +++ |
KL17 | ++ | KL35 | + + + + |
KL18 | +++ | ĐC | - |
Ghi chú: (+) rất yếu, (+ +) yếu, (+ + +) vừa, (+ + + +) mạnh
Hình 1.7 Một số khuẩn lạc phân lập tại Vịnh Xuân Đài
Hình 1.8 Định tính khả năng chuyển hóa ammonia của nhóm AOB
( Ghi chú: xanh (-), vàng (+))
Chủng vi khuẩn (1) | Đại thể (2) | Vi thể (3) | Mô tả (4) |
KL2 |
|
| Đại thể: Khuẩn lạc tròn, nhầy, màu trắng sữa, rìa răng cưa. Vi thể: Tế bào gram âm, hình que ngắn, gần tròn, tồn tại ở đạng đơn, đôi hoặc tụ thành đám. |
KL10 |
|
| Đại thể: Khuẩn lạc tròn, lồi, nhầy, màu trắng đục nhạt. Vi thể: Tế bào hình que, gram âm. |
KL11 |
|
| Đại thể: Khuẩn lạc tròn, lồi, nhầy, màu trắng hơi vàng. Vi thể: tế bào gram âm, hình que. |
KL14 |
| Đại thể: Khuẩn lạc tròn, lồi, nhầy, màu vàng nhạt. Vi thể: tế bào hình que, gram âm. | |
KL15 |
| Đại thể: Khuẩn lạc khô, nhăn, không có hình dạng cố định, màu vàng. Vi thể: Tế bào gram âm, hình que dài, nhỏ. | |
KL21 |
| Đại thể: Khuẩn lạc tròn, lồi nhầy, có màu vàng nhạt. Vi thể: Tế bào gam dương, hình que ngắn, tù ở 2 đầu, tồn tại ở dạng đơn. | |
KL26 |
|
| Đại thể: Khuẩn lạc tròn, lồi, nhầy, bóng nhớt, màu hồng dâu. Vi thể: Tế bào hình cầu, gram âm |
KL30 |
|
| Đại thể: Khuẩn lạc tròn, lồi, nhầy, màu trắng đục, khuẩn lạc nhăn ở rìa sau 48h cấy. Vi thể: Tế bào hình que, gram dương. |
1.3.3 Hình ảnh đại thể vi khuẩn, gram của các chủng vi khuẩn Bảng 1.5 Hình ảnh các chủng vi khuẩn của 10 chủng AOB